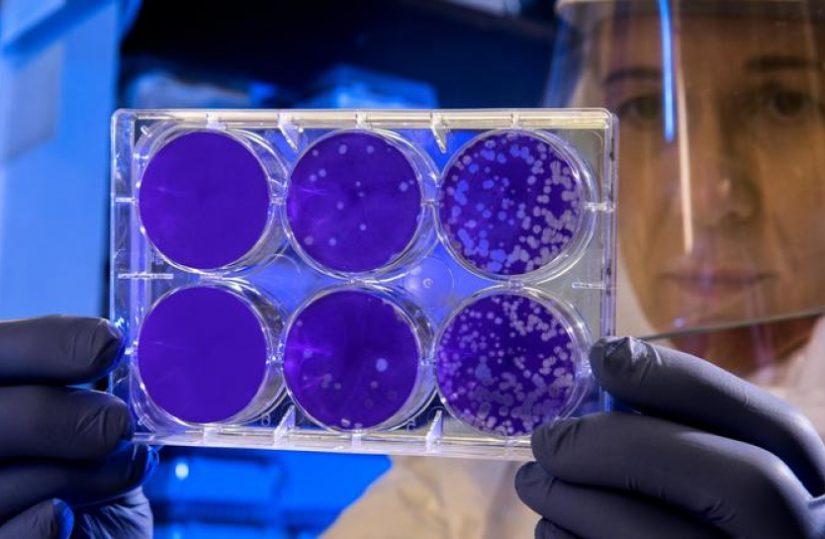

02 Set 2020
Covid-19: Anticorpos duram pelo menos 4 meses depois do diagnóstico, segundo estudo
Um relato, divulgado hoje, de testes a mais de 30 mil pessoas na Islândia, é o trabalho mais extenso já...02 Set 2020
Teleconsulta é o futuro da Medicina?
No início de 2020, a teleconsulta era considerada por muitos, uma possibilidade remota, e no espaço de semanas algo que...01 Set 2020
China e Rússia usam vacinas experimentais da covid-19 em profissionais de saúde e professores
Na China, a distribuição da vacina está a ser primeiramente nos profissionais de sectores considerados de “risco elevado”, tal como...01 Set 2020
Covid-19: mais duas mortes e 231 novos casos nas últimas 24 horas
De acordo com o boletim da DGS, desde o início da pandemia, registaram-se 58.243 casos de infeção e 1.824 mortes....01 Set 2020
MSD Portugal organiza webinar sobre Biomarcadores no Carcinoma Urotelial
O objetivo deste encontro virtual é fomentar a troca de experiências e a atualização de conhecimentos sobre Biomarcadores e o...01 Set 2020
Ministra da Saúde apela à utilização da app “StayAway Covid”
"Eu estou em processo. Creio que amanhã estará concluído", afirmou a ministra da Saúde, Marta Temido, na apresentação da aplicação...01 Set 2020
Ensaio clínico da Sanofi com resultados inconclusivos
Este ensaio de fase 3, ou seja, o estágio de teste massivo, "não atingiu o seu desfecho primário ou secundário,...01 Set 2020
Pfizer lança programa de inovação aberta para empreendedores e start-ups
Este projeto divide-se em três categorias, às quais podem concorrer empreendedores que pretendam sensibilizar a população mundial relativamente a doenças...01 Set 2020
Covid-19: Sindicatos dos médicos exigem reunir com Governo para discutir problemas do setor
“A senhor ministra da Saúde não se reúne com os sindicatos médicos desde o início da presente legislatura. Esta atitude...01 Set 2020
Covid-19: OMS pede cautela no uso de emergência de vacinas
Segundo a cientista-chefe da OMS, Soumya Swaminathan, o uso de emergência de uma vacina tem de ser ponderado "com cautela"...01 Set 2020
Covid-19: Morte dos idosos é “uma bancarrota moral” – OMS
Tedros Adhanom Ghebreyesus falava na habitual videoconferência de imprensa transmitida da sede da OMS, em Genebra, na Suíça. "A morte...01 Set 2020
Universidade do Minho em investigação mundial para tratar as 6 principais doenças psiquiátricas
Em comunicado, a UMinho refere que a investigação descobriu que há alterações do córtex, o tecido que constitui o cérebro,...01 Set 2020
Covid-19: Ministra da Saúde diz que SNS garantiu resposta assistencial nos primeiros seis meses
Marta Temido, que falava em Coimbra num evento do PS, no Convento São Francisco, assinalou de seguida a "primeira lição"...01 Set 2020
Avante!: Marcelo diz que preferia ter conhecido regras sem “insistência” para a sua divulgação
“Eu teria preferido conhecer as regras há mais tempo. Teria preferido ter conhecido as regras, não porque houve insistência para...01 Set 2020
Covid-19: DGS só reduz período de isolamento com “evidência científica robusta”
“Temos grandes expectativas, nós e toda a comunidade em todo o mundo, que venha a ser claramente estabelecimento que o...01 Set 2020